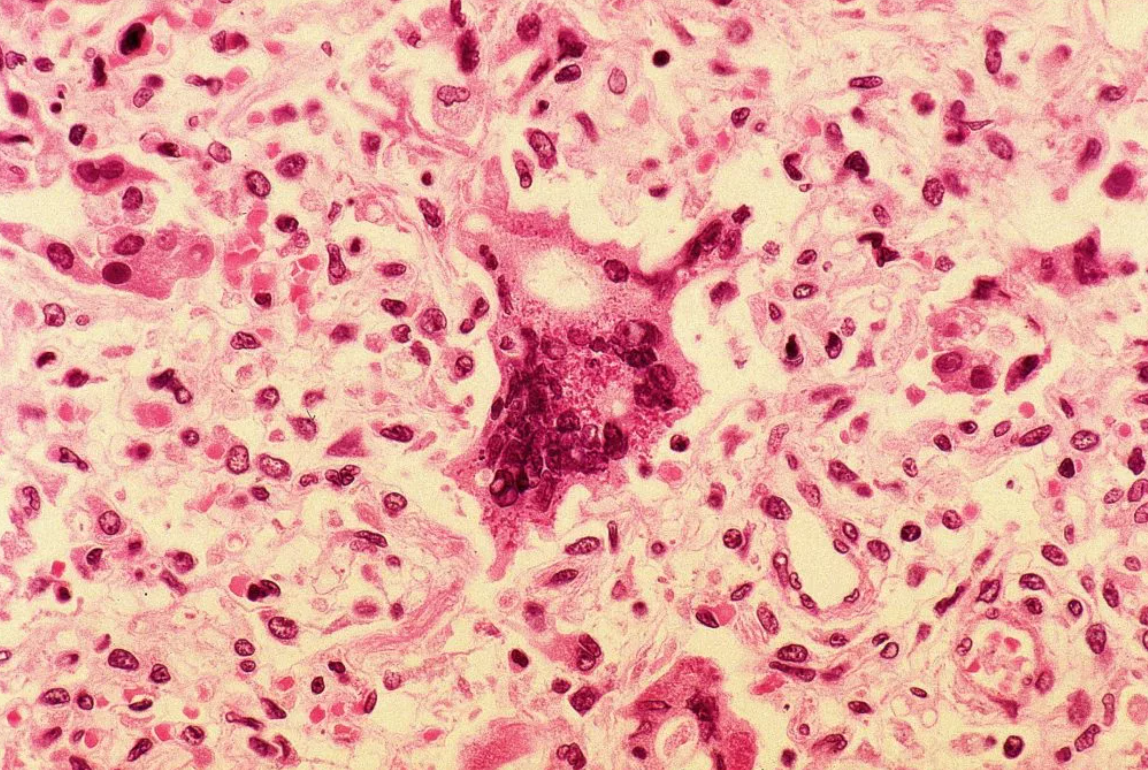

Последний из серии мощных зимних штормов в Южной Калифорнии принес еще больше осадков и потенциальное разрушительное наводнение в и без того перенасыщенный район Сан-Диего, сообщают корреспонденты nbcsandiego.com.
Шторм, который прошел над округом в воскресенье, вызвал повсеместные сильные ливни, хотя местные ливни, а также вызванные ими оползни и затопление дорог стоками были не такими серьезными, как в округах Ориндж и Лос-Анджелес, по данным Национальной метеорологической службы.
Ожидается, что общее количество осадков (в понедельник и вторник вместе взятые) составит 2-2,5 дюйма на большей части побережья и в глубине округа, однако местами может выпасть 3-4 дюйма, сообщил метеоролог NBC 7 Грег Бледсо.